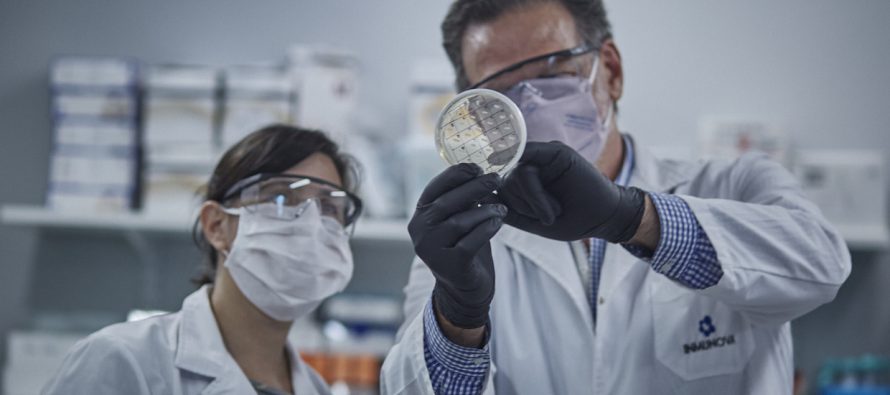

En marzo iniciarán los concursos para ingresar a organismos de ciencia y tecnología
Se trata de la primera etapa para cubrir 1.000 cargos de un total de 1.905 vacantes proyectados para 2022 y 2023.
El Ministerio de Ciencia, Tecnología e Innovación (MINCyT) y la Secretaría de Gestión y Empleo Público de la Jefatura de Gabinete de Ministros lanzan de forma coordinada el Plan Integral para el Fortalecimiento de los Recursos Humanos de los Organismos de Ciencia y Tecnología pertenecientes a la Administración Pública Nacional que, junto con el CONICET y las Universidades Nacionales, se nuclean en el Consejo Interinstitucional de Ciencia y Tecnología (CICyT).
En el marco del Plan, creado por Decisión Administrativa 970/2021 de MINCyT y Jefatura de Gabinete de Ministros, durante el período comprendido entre el 2 de marzo y el 11 de abril de 2022, se realizará el primer llamado mediante concursos públicos para el ingreso de personal de ciencia y tecnología a 16 organismos nacionales.
En busca de contar con profesionales con la más alta capacitación en las áreas de ciencia y tecnología en organismos que son esenciales para un modelo de desarrollo social, cultural, económico, productivo y ambiental, la Secretaría de Articulación Científico-Tecnológica (MINCyT) y la Secretaría de Gestión y Empleo Público, impulsan una política estructurada en los siguientes componentes:
• Incorporación de personal de Ciencia y Tecnología con la máxima calificación académica en 16 organismos que integran el CICyT
• Programa de becas post-doctorales cofinanciadas entre CONICET y los organismos que integran el CICyT.
• Mejora de las condiciones laborales del personal de los organismos que integran el CICyT.
El Plan permitirá potenciar el Sistema Nacional de Ciencia y Tecnología, articulando la capacidad formativa de Universidades de todo el país y el CONICET con el conjunto de organismos nacionales del sector.
¿Qué tipo de cargos se concursarán?
Los organismos en donde se podrán concursar los puestos son:
- Administración Nacional de Laboratorios e Institutos de Salud (ANLIS)
- Banco Nacional de Datos Genéticos (BNDG)
- Comisión Nacional de Actividades Espaciales (CONAE)
- Comisión Nacional de Energía Atómica (CNEA)
- Instituto Antártico Argentino (IAA)
- Instituto de Investigaciones Científicas y Técnicas para la Defensa (CITEDEF)
- Instituto Geográfico Nacional (IGN)
- Instituto Nacional de Desarrollo Pesquero (INIDEP)
- Instituto Nacional de Prevención Sísmica (INPRES)
- Instituto Nacional de Tecnología Agropecuaria (INTA)
- Instituto Nacional de Tecnología Industrial (INTI)
- Instituto Nacional del Agua (INA)
- Servicio Geológico Minero Argentino (SEGEMAR)
- Servicio Hidrografía Naval (SHN)
- Servicio Meteorológico Nacional (SMN)
- Administración de Parques Nacionales (APN).
Se concursarán cargos profesionales, de investigadores/as y especialistas en: ciencias de la tierra y del mar, física, biología, química, computación, desarrollo industrial y agropecuario, salud, cambio climático, etc.
¿Cómo concursar?
Durante el periodo comprendido entre el 2 de marzo y el 11 de abril de 2022 se abrirán, de forma escalonada, los concursos en los 16 organismos de ciencia y tecnología participantes y se difundirán a través de la página web del Plan. Las inscripciones se realizarán a través del Sistema Integral de Gestión y Evaluación (SIGEVA-CICYT) como plataforma común de recepción de postulaciones.
De este modo, se unificarán en un solo sitio las ofertas de los múltiples organismos participantes, posibilitando a los y las aspirantes aplicar a los procesos concursales de manera sencilla y ágil. En tanto, cada proceso concursal se desarrollará bajo los marcos normativos de cada institución convocante.
Para participar en los concursos, los/las postulantes deberán registrarse e ingresar en la plataforma SIGEVA-CICYT, identificar el o los concursos en los que se quieran presentar, completar sus antecedentes profesionales y académicos, y adjuntar la documentación respaldatoria solicitada en las Bases y Condiciones de cada concurso y en la normativa vigente.
Para recibir novedades sobre el Plan de Fortalecimiento de los Recursos Humanos de los organismos de ciencia y tecnología les invitamos a suscribirse al mailing institucional.
Fuente: Ministerio de Ciencia, Tecnología e Innovación
Related Articles
San Fernando: Municipio y Provincia proyectan obras hidráulicas para la ciudad
El intendente de San Fernando, Juan Andreotti y el presidente del Concejo Delibreante, Santiago Aparicio, recibieron al subsecretario de Recursos
Ante el pedido de Massa, el ministro Guzmán anunció que elevará el piso de Ganancias
Por Sabrina García Mediante un texto enviado al ministro de Economía de la Nación, el presidente de la Cámara de
Escobar: habilitó 50 camas en el Microestadio y en la UDP Garín para atender casos de coronavirus
En la localidad de Garín y en el marco de la pandemia del COVID-19, el intendente de Escobar, Ariel Sujarchuk
No comments
Write a commentLoading, Please Wait!
This may take a second or two.






